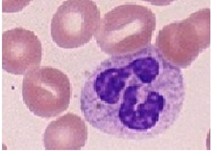
kalıp, küf içeren bir resimAçıklama otomatik olarak oluşturuldu
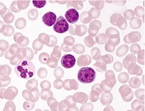
mor, leylak, renklilik, macenta içeren bir resimAçıklama otomatik olarak oluşturuldu

Hemoglobinin Yapısı ve Fizyolojik Rolü
Hemoglobin, eritrositler içerisinde bulunan ve başlıca görevi oksijenin akciğerlerden dokulara, karbondioksit ve protonların ise dokulardan akciğerlere taşınması olan bir proteindir. Yapısal olarak hem (prostetik grup) ve globin (protein kısmı) olmak üzere iki ana bileşenden oluşur. Hemoglobinin sentezi, eritropoez sırasında kemik iliğinde gerçekleşir.
Kandaki hemoglobin düzeyinin normalin altında olması anemi, normalin üzerinde olması ise polisitemi olarak tanımlanır.
Hemoglobinopati Nedir?
Hemoglobinopatiler, hemoglobin molekülünü oluşturan globin zincirlerinden birinin yapısal veya sayısal bozukluğu ile karakterize edilen, kalıtsal kan hastalıkları grubudur. Bu hastalıklar iki ana sınıfa ayrılır:
·  Talasemi sendromları (α- ve β-talasemi)
Talasemi sendromları (α- ve β-talasemi)
· Yapısal hemoglobin varyantları (HbS, HbE, HbC vb.)
Hemoglobinopatiler, klinik olarak hafif hipokromik anemiden, multiorgan tutulumu ile seyreden şiddetli ve transfüzyona bağımlı anemi tablolarına kadar geniş bir spektrumda görülebilir.
Hemoglobinopati Tanısında Mikroskobik İncelemenin Yeri
Günümüzde hemoglobinopatilerin tanısında moleküler ve genetik analizler önemli yer tutsa da periferik kan yaymalarının mikroskobik değerlendirilmesi, tanı sürecinin vazgeçilmez bir basamağıdır.
Mikroskobik boyama teknikleri sayesinde:
· Eritrosit morfolojisindeki bozukluklar
· Hemoglobin çökelmeleri
· Anormal hemoglobin formlarına bağlı hücresel değişiklikler erken dönemde saptanabilir.
Bu yöntemler, hızlı, ekonomik ve yüksek tanısal değer sunmaları nedeniyle klinik laboratuvarlarda yaygın olarak kullanılmaktadır.
Hemoglobinopati Tanısı İçin Profesyonel Mikroskobik Çözümler
GBL® HEMA-ROSE hematoloji boyaları, hemoglobinopati tanısı ve hematolojik değerlendirmeler için klinik ve araştırma laboratuvarlarının ihtiyaçlarına uygun olarak formüle edilmiştir.
Detaylı bilgi için başlığı tıklayın
Wright–Giemsa boyası, periferik kan ve kemik iliği yaymalarında hücre morfolojisinin ayrıntılı incelenmesini sağlar. Özellikle:
Wright–Giemsa boyası, periferik kan ve kemik iliği yaymalarında hücre morfolojisinin ayrıntılı incelenmesini sağlar. Özellikle:
· Hedef hücreler
· Bazofilik noktalanma
· Eritrosit boyut ve şekil anomalileri gibi bulguların değerlendirilmesinde etkilidir.
Detaylı bilgi için başlığı tıklayın
May–Grünwald Giemsa yöntemi, Romanowsky tipi boyalar arasında yer alır ve eritrosit, lökosit ve trombositlerin detaylı diferansiyasyonuna olanak tanır. Hemoglobinopatilerde görülen eritrosit morfolojik varyasyonlarının ortaya konmasında yaygın olarak kullanılır.
Detaylı bilgi için başlığı tıklayın
 Giemsa boyası, DNA’nın fosfat gruplarına özgü bağlanma özelliği sayesinde hücre çekirdeği ve sitoplazmik yapıları belirginleştirir. Eritrosit içi yapısal değişikliklerin ve eşlik eden paraziter enfeksiyonların değerlendirilmesine katkı sağlar.
Giemsa boyası, DNA’nın fosfat gruplarına özgü bağlanma özelliği sayesinde hücre çekirdeği ve sitoplazmik yapıları belirginleştirir. Eritrosit içi yapısal değişikliklerin ve eşlik eden paraziter enfeksiyonların değerlendirilmesine katkı sağlar.
Detaylı bilgi için başlığı tıklayın
 Wright boyası, hızlı ve pratik uygulaması sayesinde rutin hematoloji laboratuvarlarında sıkça tercih edilir. Metanol bazlı yapısı, ek fiksasyon gereksinimini ortadan kaldırır.
Wright boyası, hızlı ve pratik uygulaması sayesinde rutin hematoloji laboratuvarlarında sıkça tercih edilir. Metanol bazlı yapısı, ek fiksasyon gereksinimini ortadan kaldırır.
Detaylı bilgi için başlığı tıklayın
May Grünwald boyası, boya bileşeni olarak metilen mavisi, azur ve asit boya bileşeni olarak eozinin kombinasyonuna dayanan bir Romanowsky nötr boyasıdır. Kan numunelerinin veya kemik iliği numunelerinin boyanmasında kullanılmak üzere tasarlanmıştır. Hematolojide rutin olarak kullanılmaktadır. Ayrıca malarya parazitlerinin kanda aranması ve kan hücrelerinin ayrımı ve incelenmesinde kullanılır.
May Grünwald boyası, boya bileşeni olarak metilen mavisi, azur ve asit boya bileşeni olarak eozinin kombinasyonuna dayanan bir Romanowsky nötr boyasıdır. Kan numunelerinin veya kemik iliği numunelerinin boyanmasında kullanılmak üzere tasarlanmıştır. Hematolojide rutin olarak kullanılmaktadır. Ayrıca malarya parazitlerinin kanda aranması ve kan hücrelerinin ayrımı ve incelenmesinde kullanılır.
Detaylı bilgi için başlığı tıklayın
Kandaki hemoglobin miktarını; hemoglobinin, hidroklorik asit ile asit hematine dönüşmesi ve koyu kahverengi-sarı renk alması esasına dayanarak ölçmek için kullanılır.
Boyama Tekniklerinin Genel Avantajları
· Yüksek hassasiyet: Anormal eritrosit morfolojilerinin saptanmasında etkilidir
· Ekonomiklik: Düşük maliyetli ve kolay uygulanabilir
· Hızlı sonuç: Moleküler yöntemlere kıyasla kısa sürede değerlendirme imkânı
Sonuç
Hemoglobinopati tanısında mikroskobik boyama teknikleri, erken tanı, doğru sınıflama ve klinik yönlendirme açısından büyük önem taşır. Bu yöntemler, genetik analizlerle birlikte kullanıldığında tanısal doğruluğu artırarak hastaların etkin şekilde izlenmesine olanak sağlar.
Kullanıcı taleplerine bağlı olarak, setler veya set bileşenleri ayrı ayrı ve istenilen hacimlerde temin edilebilmektedir.
İletişim ve Teklif
Ürünlerimizle ilgili teknik dokümantasyon talepleriniz için kalite@gbl.com.tr, fiyat teklifi almak için teklif@gbl.com.tr adresleri üzerinden bizimle iletişime geçebilirsiniz.
Mikroskopi alanındaki diğer ürünlerimiz lütfen Mikroskopi GBL web sitemizi ziyaret ediniz.
Yazar: Ebubekir ERTAŞ / Biyolog
E-Mail: bekir@gbl.com.tr
Birim: Mikroskopi Ürün Grubu Sorumlusu
Tarihi: 25.12.2024